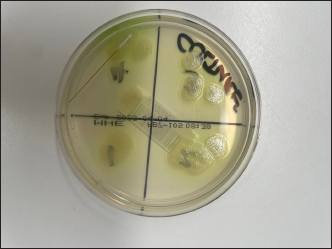

| Research Article | ||
Open Vet. J.. 2024; 14(11): 3074-3079 Open Veterinary Journal, (2024), Vol. 14(11): 3074-3079 Research Article An assessment of bacterial transmission via rebound tonometry: An in vitro pilot studyJonathan Wood*, Martyn King and Anita DuttonPerth Animal Eye Hospital, Manning, Perth, Western Australia *Corresponding Author: Jonathan Wood. Perth Animal Eye Hospital, Manning, Perth, Western Australia. Email: Jonathan [at] pertheyevet.com.au Submitted: 12/09/2024 Accepted: 22/10/2024 Published: 30/11/2024 © 2024 Open Veterinary Journal
AbstractBackground: Bacterial contamination of medical equipment is a significant risk in both human and veterinary medicine, leading to potential cross-contamination between clinicians, technicians, patients, and healthcare professionals. Pathogens can persist on surfaces, resulting in healthcare-associated infections. Tonometry used to measure intraocular pressure for diagnosing conditions like glaucoma and uveitis, is crucial in both human and veterinary care. However, there is limited information on bacterial transmission through reused tonometer probes in veterinary patients. This pilot study aimed to explore the potential for cross-contamination of bacteria via a rebound tonometer probe using bacterial isolates linked to bacterial ulcerative keratitis in dogs. Aim: To evaluate the potential for bacterial transmission via rebound tonometry using the ICare® TONOVET Plus in a controlled laboratory environment. The study focused on two bacterial isolates commonly implicated in canine bacterial ulcerative keratitis: Pseudomonas aeruginosa and beta-haemolytic Streptococcus. Methods: Bacterial cultures were inoculated on blood agar and MacConkey agar plates. Tonometer probes were used to perform multiple corneal rebounds (CRs) readings on known bacterial samples, followed by multiple CR readings on agar growth plates, incubation, and re-examination of the agar plates for evidence of bacterial transfer. Controls included plates where the probes were only used on sterile agar. Results: Bacterial transmission was detected with distinct bacterial colonies corresponding to individual CR readings on the plates inoculated with Pseudomonas and beta-haemolytic Streptococcus. A control plate exhibited a single bacterial colony, likely due to inadvertent contamination. Conclusion: The results indicate that bacterial transmission via rebound tonometer probes is possible. Although this was an in vitro study, the findings raise concerns about cross-contamination in clinical practice. Changing tonometer probes between patients, particularly after those with bacterial ulcerative keratitis is advised until further investigation into the in vivo bacterial transmission is investigated. Keywords: Bacteria, Contamination, Culture, Tonometry. IntroductionBacterial contamination of medical equipment can cause cross-contamination between clinicians, technicians, patients, and healthcare professionals (Smith et al., 2024). Cross-contamination poses a significant risk in veterinary and human medicine. Pathogens can persist on surfaces for extended periods (Kramer et al., 2006), leading to healthcare-associated infections (Gentile et al., 2020) and this environmental contamination can result in serious infections. In human ophthalmology, contamination rates, range from 11.7% to 82% for specific diagnostic tools. This high level of contamination represents a significant health concern, resulting in the potential transmission between patients and healthcare staff (Gentile et al., 2020). A recent publication (Smith et al., 2024) demonstrated the high baseline bacterial contamination of indirect ophthalmoscopes and condensing lenses in a veterinary setting (Smith et al., 2024), whilst another study demonstrated contamination rates of ophthalmic equipment and examination rooms were 32.9% and 42.9 %, respectively (Gentile et al., 2020). Previous studies have also demonstrated bacterial contamination of goniolenses which have direct contact with the cornea (Grundon et al., 2018). Whilst the cornea usually prevents bacterial invasion through various defenses, the cornea becomes susceptible to ulcerative keratitis and bacterial infection when these defenses fail or are compromised (Hindley et al., 2016). Such infections can progress rapidly, driven by bacterial toxins and host factors, potentially leading to poor visual outcomes or even loss of eye (Ollivier, 2003). Tonometry is a frequently performed diagnostic test in human and veterinary ophthalmology. Estimating intraocular pressure (IOP) is a crucial part of the ophthalmic examination. Accurate IOP measurements are an essential part of a complete ophthalmic examination. There are a variety of handheld tonometers available, and their use is well reported in the literature (Rajak et al., 2006; Minella et al., 2021; Passareli et al., 2021; Kapeller et al., 2024; Michaud and Lesne, 2024; Okur et al., 2023, 2024). The most used tonometers used in clinical veterinary practice being applanation or rebound tonometers. These units have different contact surfaces and frequency of applications to get an average reading. Previous reports have examined the transmission of bacteria via equipment (Kramer, 2006; Rajak et al., 2006; Sobolewska et al., 2018; Smith et al., 2024). Still, little information is available on the transmission of bacteria via the reuse of tonometer probes or covers in veterinary patients. This pilot study aimed to demonstrate the potential in vitro cross-contamination of bacteria from a sample of known bacterial contamination to a growth media using a rebound tonometer probe. The bacterial isolates used include the two most commonly encountered bacterial keratitis in dogs (Ollivier, 2003; Hindley et al., 2016; Hewitt et al., 2020; Deniaud and Tee, 2023). Material and MethodsRebound tonometryThe ICare® TONOVET Plus (ICare®Finland Oy) (TVP) is a rebound tonometer routinely used in veterinary practice. It utilizes a small, lightweight probe with a rounded plastic tip that is propelled toward the cornea, briefly contacting the surface before rebounding back toward the machine. The IOP is calculated based on the deceleration of the probe. Each intraocular measurement is an average of six readings (Knollinger et al., 2005; Briesen et al., 2010; Okur et al., 2024). MethodsTwo bacterial isolates, Pseudomonas aeuroginosa and beta-hemolytic Streptococcus, were chosen for the study. Pure growth sample plates were used from a reference laboratory (Vetnostics, Jandakot, WA). Sample growth plates were selected as follows: horse blood agar (HBA) for beta-hemolytic Streptococcus and MacConkey agar (MA) for P. aeuroginosa. The growth and control plates were divided into four zones, numbered one through four. The TVP was cleaned with 70% isopropyl alcohol (Isopropyl Alcohol 70% Orion Laboratories, Australia) before use. The operator wore sterile surgical gloves throughout the investigation and gloves were changed between each reading. Bacterial collection and growthSix culture plates were used during the investigation. Two were pure growth sample plates supplied by the laboratory, and two HBA and two MA. One HBA and one MA plate would serve as the negative control to ensure that the new tonometer probes used in the experiment did not have bacterial contamination. Each of the HBA and MA plates were divided into four zones. The tonometer was used in the same way that a tonometry reading would be taken in practice, to inoculate the test plates. We hypothesized that there may be an increased risk of transmission with an increase in rebounds. Therefore, inoculations were done in multiples of six as the TVP averages six rebounds to calculate an IOP. Procedure1: A new tonometer probe was inserted into the tonometer, and six standard rebound touches were performed in zone one of the control growth plates (control reading). 2: The same probe was then used for six standard rebound touches on the known bacterial culture plate. 3: The same probe was then used for six standard rebound touches in zone one of the bacterial test plate. 4: The tonometer probe was removed, and the sterile gloves were changed in an aseptic manner. 5: A new tonometer probe was inserted into the tonometer, and steps 1–4 were repeated. However, 12 touches were performed for zone 2, and 18 touches were performed for zone 3. 6: A new tonometer probe was manually rubbed into the surface of the bacterial plate. Some bacterial growth was lifted and embedded into the test plate in zone four to provide positive control. The probe was also left embedded in the agar plate. The process was performed for both bacterial isolates. Pseudomonas was inoculated on the MA, and beta-hemolytic Streptococcus was inoculated onto the HBA. The negative control plates were the same growth medium as the medium that was selected for the bacterial culture. Microbiology protocol1) The HBA was then incubated at a temperature range of 33–39 degrees Celsius (average 37°C) under a raised carbon dioxide atmosphere (5.4%) for optimal visibility of bacterial growth. 2) The MA was incubated at a temperature of 33–39 degrees Celsius (average 37°C) in an oxygen incubator. The bacterial plates were examined by a boarded veterinary clinical pathologist 24 hours and 48 hours after incubation. Ethical approvalNot needed for this study. ResultsThe HBA control plate was negative in all zones (Fig. 1.) The MA control plate was negative, apart from a single colony in zone two (Fig. 2). Bacterial growth was seen in all zones of the inoculated plates 48 hours after incubation. This was true for the beta-hemolytic Streptococcus species and the Pseudomonas aeruginosa (Figs. 3 and 4). Distinct colonies on both agar plates correlate to sites of the individual rebounds. DiscussionThe results demonstrate that bacterial transmission using a tonometer in the way it is utilized in clinical practice, is possible in a laboratory setting. This contrasts with one study looking at the potential transmission of bacterial transmission with the Icare (Icare Finland Oy, 02600 Espoo, Finland), a human rebound tonometer. This study demonstrated that bacterial contamination did not occur in patients with healthy corneas (Briesen et al., 2010). The study also demonstrated, via electron microscopic examination, a lack of significant cellular debris on the tonometer probe after repeated use. It must be noted that they performed the study on patients with healthy corneas with no signs of bacterial keratitis. During use, a tonometer probe only contacts the cornea for a short time. Since bacterial agar plates are not a substitute for a normal cornea, several factors could have played a role in the transmission. Firstly, the agar is much softer than a healthy cornea, allowing the tonometer probe to penetrate deeper into the agar plate, enhancing the surface area in contact with the bacteria. Secondly, because the agar plates are softer, the tonometer probe may have been in contact with the bacteria for an extended period. These factors could increase the number of bacteria transferred to the tonometer probe from the plate, and from the tonometer probe to the growth plate. In patients with bacterial keratitis and keratomalacia, the cornea is subjectively softer which may allow the tonometer probes to have enhanced penetration and contact time. Thirdly, agar plates are designed for bacterial growth whereas normal cornea is not. We cannot be dogmatic that bacterial inoculation will cause infection in a healthy cornea. However, if the normal corneal defense mechanisms are compromised, such as in the case of corneal ulceration or surgery then bacterial transmission may have significant consequences and potentially result in loss of the globe.
Fig. 1. Blood agar control—demonstrating no growth We chose to repeat the rebound in factors of six as this correlates to a single IOP reading on the TVP. Six rebounds relate to 1 reading, 12 rebound to 2 readings, and 18 rebound to 3 readings. It is common practice for repeat readings to be taken during an examination. However, since bacterial growth was noted on growth plates after one reading (six rebounds) it is apparent that transmission can occur with one complete reading, indicating the number of bacteria that were collected from the known bacterial colonies was enough to inoculate the growth plates. Comparison between the zones of the culture plates to measure the amount of bacterial growth and growth rates was not performed but could have been an interesting adjunct to the study.
Fig. 2. MacConkey’s Agar Control—demonstrating growth in zone two as discussed. Note the single colony.
Fig. 3. Blood Agar culture plate—demonstrating bacterial growth in all four zones. Note the individual colonies associated with each probe contact. A single bacterial colony of Pseudomonas spp. was noted in zone two of the control plate (Fig. 4). This may have been due to human error in the inoculation transfer or may have been a result of environmental contamination. Only one bacterial colony is noted whereas the rest of the zone is free from other bacterial colonies despite multiple rebound touches. No bacterial growth was seen along the shaft of the TVP probe which was embedded in zone four. This would support the supposition that the probes were not contaminated prior to use. While the manufacturer recommends changing the tonometer probes between uses, the authors have found that this is not common practice. Our findings are concerning, especially in cases of bacterial keratitis, when the usual corneal rigidity may be reduced, allowing the tonometer probe to have increased contact with potential pathogens. Since many of these pathogens exist on surfaces for prolonged periods, tonometer probes are a possible source of cross-contamination especially when used in patients with keratomalacia. Bacterial keratitis is caused by opportunistic and pathogenic bacteria that can infect the corneas of both canine and feline patients. Transfer of these bacteria via rebound tonometry has been shown to be possible. Contamination may potentially go unnoticed until the probe is reused on subsequent patients. Based on our study, we recommend exercising caution when performing tonometry on patients with infectious ulcerative keratitis and advise replacing the tonometer probe between patients to reduce the risk of cross-contamination. A limitation of our study is that it is an in-vitro study, and bacterial transmission via tonometry has yet to be demonstrated to occur in vivo in veterinary patients. However, the results strongly suggest that cross contamination and infection are feasible and that care should be taken in clinical practice as patients who are examined within an ophthalmic practice may be more susceptible to disease from this contamination especially when it could be argued that most patients encountered in veterinary ophthalmic practice do not have “healthy” eyes.
Fig. 4. MacConekey’s Agar growth plate—demonstrating bacterial growth. We did not perform repeat testing for statistical analysis as this was a proof-of-concept study. Our aim was to see if bacterial transmission was possible, which was demonstrated. Further investigations are warranted to demonstrate in vivo contamination and transmission. Further investigationsDisinfection protocols of the TVP probes were not assessed as part of this study. Many cleaning agents are toxic to the corneal epithelium, and these cleaning agents could potentially cause damage to the cornea during normal use. Several disinfection protocols for acrylic plastic tonometer tips were assessed in one study which found a variable ability to eradicate pathogenic bacteria and viruses (Cillino et al., 2007). Several bacterial isolates and cleaning protocols would need to be assessed to ensure a suitable cleaning protocol is found. Electron microscopy would help indicate whether there is increased bacterial contamination and cellular debris on probes used in patients with bacterial keratitis. It would also be interesting to examine if more cellular debris is present on the probes after use in animals with healthy corneas compared to humans. Potential damage to the polymethylmethacrylate (PMMA) head from repeated cleaning (Briesen et al., 2010) is also a concern as it may increase bacterial adherence and promote biofilm formation, complicating repeated disinfection. Examining the cleaned probes using electron microscopy could be valuable in assessing any degradation of the probe tip caused by the cleaning process. Further in vivo investigations involving taking tonometer probes and sending them for culture after contact with known bacterial keratitis could help in determining the risk of contamination in vivo. A corneal bacterial culture sample could be taken from the cornea along with a cytological sample and a culture from the TVP probe used during the examination. The cytology would help demonstrate that bacterial keratitis is present, and the bacterial culture would allow the identification of the bacterial species. A comparison between the two bacterial samples could be performed by looking at the bacterial isolates, colony sizes, and growth rates. Another factor worth assessing would be the duration of bacterial viability on the surface of the probe. There is often a time lapse between consultations, and the duration of time between consultations has an impact on bacterial transmission. For example, do the bacteria denature due to drying out on the probe or are they protected by a biofilm. This study only looked at the possible transmission of two pathogens associated with bacterial keratitis in animals. We did not assess other known bacterial pathogens that are involved in corneal ulceration; however, further investigations looking at whether certain bacteria are more likely to be transmitted than others would be interesting. It has been shown that adenovirus is transmissible via tonometry and clinical staff in human patients (Warren et al. 1989; Rajak et al., 2006; Briesen et al., 2010). Further research into the possibility of common viral corneal diseases, such as herpes virus in cats, is another area of further research. In summary, the authors recommend changing the tonometer probe between patients, especially after the probe has been in contact with known bacterial keratitis. AcknowledgmentsThe authors would like to thank Vetnostic laboratories, Jandakot, and Dr Leanne Twomey for their help in the study. Conflict of interestThe authors have no conflict of interest to declare. FundingNo external funding. Authors’ contributionsDr Jonathan Wood—Paper writing, laboratory work, study concept and structure. Dr Martyn King—Paper revision, and study design. Dr Anita Dutton—Paper review and revision. Data availabilityData are available on further request. ReferencesBriesen, S., Schulze Schwering, M., Roberts, H., Kollmann, M., Stachs, O. and Behrend, D. 2010. Minimal cross-infection risk through Icare rebound tonometer probes: a useful tool for IOP-screenings in developing countries. Eye 24(7), 1279–1283. Cillino, S., Casuccio, A., Giammanco, G.M., Mammina, C., Morreale, D. and Di Pace, F. 2007. Tonometers and infectious risk: myth or reality? Efficacy of different disinfection regimens on tonometer tips. Eye 21(4), 541–546. Deniaud, M. and Tee, E. 2023. Susceptibility pattern of bacterial isolates in equine ulcerative keratitis: implications for empirical treatment at a university teaching hospital in Sydney. Aust. Vet. J. 101(3), 115–120. Gentile, D., Allbaugh, R.A., Adiguzel, M.C., Kenne, D.E., Sahin, O. and Sebbag, L. 2020. Bacterial cross-contamination in a Veterinary ophthalmology setting. Front. Vet. Sci. 7, 571503. Grundon, R., Scurrell, E., Mould, J., Hayton-Lee, E. and Heinrich, C. 2018. An investigation into the bacterial contamination of goniolenses in use in clinical practice. Vet. Ophthalmol. 21(5), 459–463. Hewitt, J.S., Allbaugh, R.A., Kenne, D.E. and Sebbag, L. 2020a. Prevalence and antibiotic susceptibility of bacterial isolates from dogs with ulcerative keratitis in midwestern united states. Front. Vet. Sci. 7, 583965. Hewitt, J.S., Allbaugh, R.A., Kenne, D.E. and Sebbag, L. 2020b. Prevalence and antibiotic susceptibility of bacterial isolates from dogs with ulcerative keratitis in midwestern united states. Front. Vet. Sci. 7, 583965. Hindley, K.E., Groth, A.D., King, M., Graham, K. and Billson, F.M. 2016a. Bacterial isolates, antimicrobial susceptibility, and clinical characteristics of bacterial keratitis in dogs presenting to referral practice in Australia. Vet. Ophthalmol. 19(5), 418–426. Hindley, K.E., Groth, A.D., King, M., Graham, K. and Billson, F.M. 2016b. Bacterial isolates, antimicrobial susceptibility, and clinical characteristics of bacterial keratitis in dogs presenting to referral practice in Australia. Vet. Ophthalmol. 19(5), 418–426. Kapeller, L.E., Buckman, P.N., Wang, S. and Komáromy, A.M. 2024. Validation of the Reichert® Tono-Vera® Vet rebound tonometer in normal ex vivo canine eyes. Vet. Ophthalmol. 27(3), 290–293. Knollinger, A.M., La Croix, N.C., Barrett, P.M. and Miller, P.E. 2005, Evaluation of a rebound tonometer for measuring intraocular pressure in dogs and horses. J. Am. Vet. Med. Assoc. 227(2), 244–248. Kramer, A., Schwebke, I. and Kampf, G. 2006. How long do nosocomial pathogens persist on inanimate surfaces? a systematic review. BMC Infect. Dis. 6, 130. Michaud, B. and Lesne, F. 2024. Comparing the intraocular pressure values obtained with a rebound tonometer (TONOVET Plus) and an indentation tonometer (IOPvet) in dogs with and without ocular disease. Vet. Rec. 194(12), e4269. Minella, A.L., Kiland, J.A., Gloe, S. and McLellan, G.J. 2021. Validation and comparison of four handheld tonometers in normal ex vivo canine eyes. Vet. Ophthalmol. 24(Suppl. 1), 162–170. Okur, S., Yanmaz, L.E., Senocak, M.G., Ersöz, U., Gölgeli, A. and Turgut, F. 2023. Comparison of intraocular pressure in New Zealand White rabbits measured using rebound and applanation tonometers and four different methods of physical restraint. N. Z. Vet. J. 71(5), 251–258. Okur, S., Yanmaz, L.E., Çınar, H., Gölgeli, A., Orhun, Ö.T. and Turgut, F. 2024. Comparison of first, second, and third versus the average of six probe-corneal touches for intraocular measurement of two rebound tonometers in healthy horses. J. Equine Vet. Sci. 136, 105074. Ollivier, F.J. 2003. Bacterial corneal diseases in dogs and cats. Clin. Tech. Small Anim. Pract. 18(3), 193–198. Passareli, J.V.G.C., Nascimento, F.F., Estanho, G.J.G., Ricci, C.L., Kanashiro, G.P. and Giuffrida, R. 2021. Comparison among TonoVet, TonoVet Plus, Tono-Pen Avia Vet, and Kowa HA-2 portable tonometers for measuring intraocular pressure in dogs. Vet. World. 14(9), 2444–2451. Rajak, S.N., Paul, J., Sharma, V. and Vickers, S. 2006. Contamination of disposable tonometer prisms during tonometry. Eye. 20(3), 358–361. Smith, J.L., Tzouganakis, I., Allen, R., Adams, V.J. and Rhodes, M. 2024. An assessment of bacterial contamination of indirect ophthalmoscopes and condensing lenses used in clinical practice: A multi-center study. Vet. Ophthalmol. 27(4), 347–356. Sobolewska, B., Buhl, M., Liese, J. and Ziemssen, F. 2018, Slit lamps and lenses: a potential source of nosocomial infections? Eye 32(6), 1021–1027. | ||
| How to Cite this Article |
| Pubmed Style Wood JA, King M, Dutton A. An assessment of bacterial transmission via rebound tonometry: An in vitro pilot study. Open Vet. J.. 2024; 14(11): 3074-3079. doi:10.5455/OVJ.2024.v14.i11.36 Web Style Wood JA, King M, Dutton A. An assessment of bacterial transmission via rebound tonometry: An in vitro pilot study. https://www.openveterinaryjournal.com/?mno=219470 [Access: June 22, 2026]. doi:10.5455/OVJ.2024.v14.i11.36 AMA (American Medical Association) Style Wood JA, King M, Dutton A. An assessment of bacterial transmission via rebound tonometry: An in vitro pilot study. Open Vet. J.. 2024; 14(11): 3074-3079. doi:10.5455/OVJ.2024.v14.i11.36 Vancouver/ICMJE Style Wood JA, King M, Dutton A. An assessment of bacterial transmission via rebound tonometry: An in vitro pilot study. Open Vet. J.. (2024), [cited June 22, 2026]; 14(11): 3074-3079. doi:10.5455/OVJ.2024.v14.i11.36 Harvard Style Wood, J. A., King, . M. & Dutton, . A. (2024) An assessment of bacterial transmission via rebound tonometry: An in vitro pilot study. Open Vet. J., 14 (11), 3074-3079. doi:10.5455/OVJ.2024.v14.i11.36 Turabian Style Wood, Jonathan Alexander, Martyn King, and Anita Dutton. 2024. An assessment of bacterial transmission via rebound tonometry: An in vitro pilot study. Open Veterinary Journal, 14 (11), 3074-3079. doi:10.5455/OVJ.2024.v14.i11.36 Chicago Style Wood, Jonathan Alexander, Martyn King, and Anita Dutton. "An assessment of bacterial transmission via rebound tonometry: An in vitro pilot study." Open Veterinary Journal 14 (2024), 3074-3079. doi:10.5455/OVJ.2024.v14.i11.36 MLA (The Modern Language Association) Style Wood, Jonathan Alexander, Martyn King, and Anita Dutton. "An assessment of bacterial transmission via rebound tonometry: An in vitro pilot study." Open Veterinary Journal 14.11 (2024), 3074-3079. Print. doi:10.5455/OVJ.2024.v14.i11.36 APA (American Psychological Association) Style Wood, J. A., King, . M. & Dutton, . A. (2024) An assessment of bacterial transmission via rebound tonometry: An in vitro pilot study. Open Veterinary Journal, 14 (11), 3074-3079. doi:10.5455/OVJ.2024.v14.i11.36 |